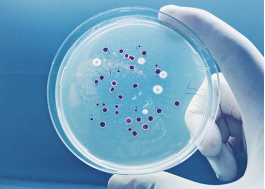

生物技术产品的冻干工艺
生物技术产品的冻干工艺
源自酶、微生物等生命体的生物技术产品,需通过稳定化处理以延长保质期并便于运输。冻干技术已成为生物科技行业的重要环节—— 通过去除生物制品中的水溶液与溶剂,可有效防止成分降解,同时保留药物递送所需的蛋白质活性。在当前行业追求低成本高产能的目标下,优化冻干工艺尤为关键。
灵活、性能驱动的 BioTech 冻干解决方案
无论处于研发阶段还是规模化生产阶段,Millrock 专家团队均能为您定制适配生物科技需求的冻干解决方案。我们珍视与客户的长期合作关系,致力于提供缩短处理时间、提升产能、保障批次一致性及优化产品质量的技术工具。
Millrock Technology 的工程团队在产品设计中充分考量客户的应用挑战,打造更耐用、更可靠的设备。从制冷系统设计到仪器配置,每个组件均经过精准工程化设计,采用高品质材料,确保与您的珍贵冻干产品工艺完美匹配。









